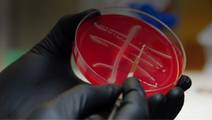
ReachMD Healthcare Image
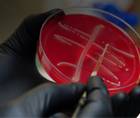
ReachMD Healthcare Image

What Your Patients Are Talking About
The concerns of our patients are central to all of us, but it can be difficult to stay ahead of the news and trending topics that affect people's outlook on health prior to visiting our offices. "What Your Patients Are Talking About" provides you with valuable insights on subjects of interest to patients from across the spectrum of health and disease. Dr. Brian McDonough, Clinical Professor of Family Medicine at Temple University School of Medicine, Chairman of the Family Medicine Department and Chief Medical Information Officer at St. Francis Hospital, delivers timely, easy-to-digest updates to help you connect with your patients as a trusted resource.
31-45 of 89
No Calories Left Behind: Google Glass as a Dietary Aid
What Your Patients Are Talking AboutNo Calories Left Behind: Google Glass as a Dietary Aid
Researchers Develop Patch for Blood Sugar Regulation in Diabetics
What Your Patients Are Talking AboutResearchers Develop Patch for Blood Sugar Regulation in Diabetics
Hot Flashes: More Than Just Nuisances for Menopausal Women
What Your Patients Are Talking AboutHot Flashes: More Than Just Nuisances for Menopausal Women
Medical Errors: A Silent But Leading Cause of Death in America
What Your Patients Are Talking AboutMedical Errors: A Silent But Leading Cause of Death in America
Sports for Teens: A Protectant Against Drug Use?
What Your Patients Are Talking AboutSports for Teens: A Protectant Against Drug Use?
India Shifts Health Policies to Curb Unapproved Drug Sales
What Your Patients Are Talking AboutIndia Shifts Health Policies to Curb Unapproved Drug Sales
- advertisement
CDC Reports American Case of Colistin-Resistant Superbug
What Your Patients Are Talking AboutCDC Reports American Case of Colistin-Resistant Superbug
Traditions Unwrapped: The Startling Risks of Swaddling Babies
What Your Patients Are Talking AboutTraditions Unwrapped: The Startling Risks of Swaddling Babies
Working Too Much: How Extended Hours Affect Cardiac Health
What Your Patients Are Talking AboutWorking Too Much: How Extended Hours Affect Cardiac Health
Recognizing Teen Depression: Updated Screening Guidelines
What Your Patients Are Talking AboutRecognizing Teen Depression: Updated Screening Guidelines
The Surprising Brain Health Benefits of Complex Jobs
What Your Patients Are Talking AboutThe Surprising Brain Health Benefits of Complex Jobs
Insomnia Linked to Increased Risk of Stroke
What Your Patients Are Talking AboutInsomnia Linked to Increased Risk of Stroke
- advertisement
Alternative Indications for In Vitro Fertilization: Do the Benefits Outweigh Risks?
What Your Patients Are Talking AboutAlternative Indications for In Vitro Fertilization: Do the Benefits Outweigh Risks?
The Truth About Vitamin D Supplements: How Effective Are They Anyway?
What Your Patients Are Talking AboutThe Truth About Vitamin D Supplements: How Effective Are They Anyway?
Can Strawberries Stave Off Alzheimer's Disease?
What Your Patients Are Talking AboutCan Strawberries Stave Off Alzheimer's Disease?